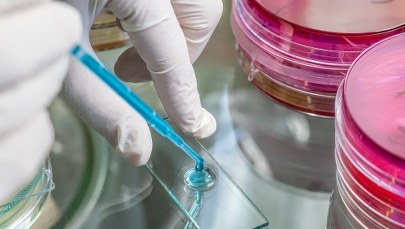
​Wyłudzenia danych na legionellę. Policja ostrzega przed oszustami

W nocy z poniedziałku na wtorek funkcjonariusze z Placówki Straży Granicznej zatrzymali siedmiu obywateli Turcji. Próbowali oni nielegalnie przekroczyć polską granicę w Chyżnem.
Nielegalni migranci wpadli podczas kontroli drogowej w rejonie byłego przejścia granicznego ze Słowacją. Funkcjonariusze SG ujawnili w pojeździe siedem osób.
Okazało się, że zatrzymani to rodzina Turków narodowości kurdyjskiej: rodzice wraz z piątką swoich małoletnich dzieci w wieku od roku do 14 lat. Uciekli z kraju, ponieważ obawiali się prześladowań. W Polsce złożyli wnioski o ochronę międzynarodową.
Do czasu rozpatrzenia wniosków przez Szefa Urzędu ds. Cudzoziemców, rodzina będzie przebywać w ośrodku dla cudzoziemców.